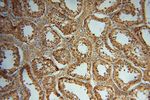
UFSP2 Antibody in Immunohistochemistry (Paraffin) (IHC (P))
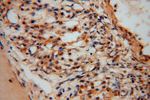
UFSP2 Antibody in Immunohistochemistry (Paraffin) (IHC (P))

Search
Proteintech
UFSP2 Polyclonal Antibody
{{$productOrderCtrl.translations['antibody.pdp.commerceCard.promotion.promotions']}}
{{$productOrderCtrl.translations['antibody.pdp.commerceCard.promotion.viewpromo']}}
{{$productOrderCtrl.translations['antibody.pdp.commerceCard.promotion.promocode']}}: {{promo.promoCode}} {{promo.promoTitle}} {{promo.promoDescription}}. {{$productOrderCtrl.translations['antibody.pdp.commerceCard.promotion.learnmore']}}
产品信息
16999-1-AP
种属反应
宿主/亚型
分类
类型
抗原
偶联物
形式
浓度
规格
纯化类型
保存液
内含物
保存条件
运输条件
产品详细信息
The MW of this protein is 53 kDa, and this antibody specifically recognizes the 53 kDa protein.
Immunogen sequence: MLEMSTSLA AVTPIIERES GGHHYVNMTL PVDAVISVAP EETWGKVRKL LVDAIHNQLT DMEKCILKYM KGTSIVVPEP LHFLLPGKKN LVTISYPSGI PDGQLQAYRK ELHDLFNLPH DRPYFKRSNA YHFPDEPYKD GYIRNPHTYL NPPNMETGMI YVVQGIYGYH HYMQDRIDDN GWGCAYRSLQ TICSWFKHQG YTERSIPTHR EIQQALVDAG DKPATFVGSR QWIGSIEVQL VLNQLIGITS KILFVSQGSE IASQGRELAN HFQSEGTPVM IGGGVLAHTI LGVAWNEITG QIKFLILDPH YTGAEDLQVI LEKGWCGWKG PDFWNKDAYY NLCLPQRPNM I (120-469 aa encoded by BC010493)
靶标信息
Ubiquitin-fold modifier 1 (Ufm1)-specific protease 2 (UfSP2) is a cysteine protease that is responsible for the release of Ufm1 from Ufm1-conjugated cellular proteins, as well as for the generation of mature Ufm1 from its precursor.
仅用于科研。不用于诊断过程。未经明确授权不得转售。
生物信息学
蛋白别名: FLJ11200; Ufm1-specific protease 2; UfSP2; unnamed protein product
基因别名: 1810047C23Rik; BHD; C4orf20; DEE106; RGD1311161; SEMDDR; UFSP2
UniProt ID: (Human) Q9NUQ7, (Rat) Q5XIB4, (Mouse) Q99K23
Entrez Gene ID: (Human) 55325, (Rat) 361151, (Mouse) 192169